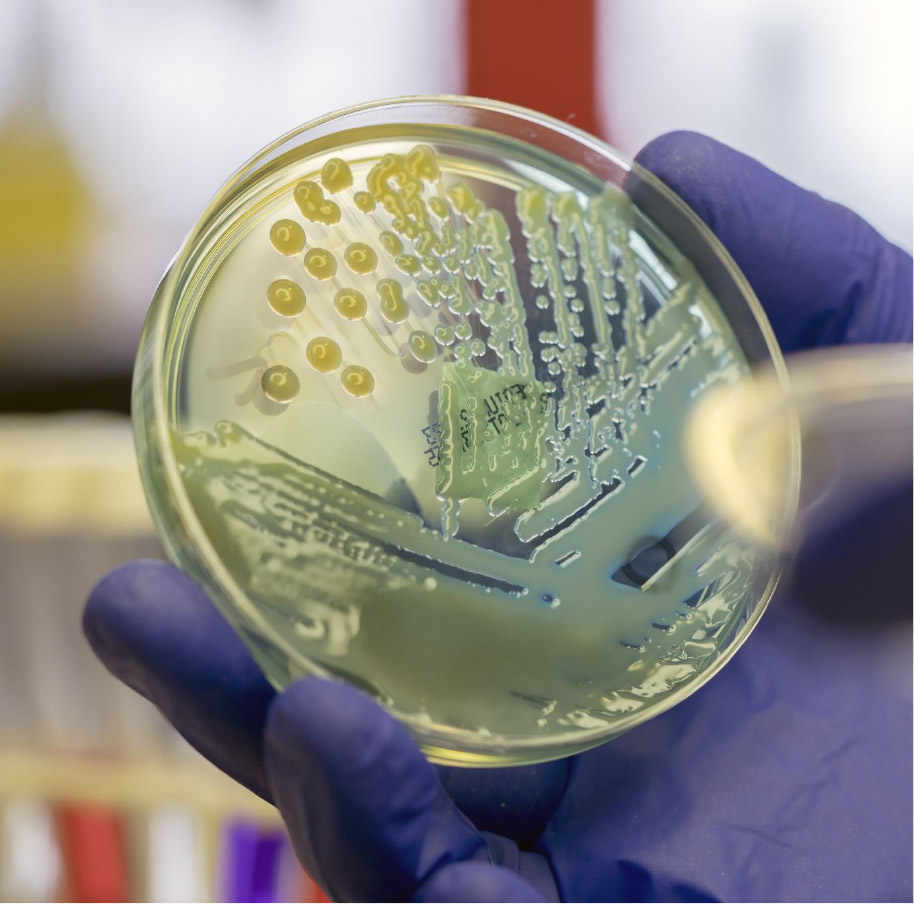

Case Report 2025
Lorem ipsum dolor sit amet, consetetur sadipscing elitr, sed diam nonumy eirmod tempor invidunt ut labore et dolore magna aliquyam erat, sed diam voluptua. At vero eos et accusam et justo duo dolores et ea rebum. Stet clita kasd gubergren, no sea takimata sanctus est Lorem ipsum dolor sit amet.
» Case Report startenPatientin mit Schluckbeschwerden
Ein interaktiver Patientenfall
Univ.-Prof. Dr. Klaus Geissler
Ass.-Prof. Priv.-Doz. Dr. David Haschka, PhD
OÄ Dr.in Sigrid Machherndl-Spandl
Unterstützt von

Krankengeschichte
Eine 20 Jahre alte Frau kommt in die Notaufnahme. Sie klagt über Schmerzen im Rachen und auf der linken Halsseite. Sie hat Fieber und einen übel-riechenden Atem. Das Fieber und die Schmerzen bestehen bereits seit etwa 10 Tagen.
Vorgeschichte
6 Tage vor dem aktuellen Besuch in der Notaufnahme war die Patientin beim praktischen Arzt. Dieser stellte geschwollene Rachenmandeln, vor allem auf der linken Seite fest.
Der Streptokokken-Schnelltest war negativ, ebenso ein Labortest auf Epstein-Barr-Virus.
Der Allgemeinmediziner gab ihr eine einmalige Dexamethason-Injektion und hat sie wieder nach Hause geschickt.
Anm.: Also weder klassische bakterielle Angina tonsillaris noch ein Pfeiffersches Drüsenfieber.
Anamnese
Die Patientin hatte keine Vorerkrankungen und keine Dauermedikation, sie war Nichtraucherin und trank keinen Alkohol.
Keine Allergien bekannt.
Worauf würden Sie bei der klinischen Untersuchung besonders achten
Klinische Untersuchungen
In der körperlichen Untersuchung fielen eine Schwellung der Hals-
lymphknoten und Schmerzen bei Rechtsrotation in der Halswirbelsäule auf.
Generelles Erscheinungsbild
schlechter Allgemeinzustand, ängstlich aufgrund ihres Zustandes
Vitalzeichen
Temperatur 39,5
Blutdruck 110/55
Herzfrequenz 130 bpm
Atemfrequenz 28 Atemzüge/min.
Sauerstoffsättigung 98% bei Raumluft
Lunge
Auskultation o.B.
Herz
tachykard, rhythmisch
Auskultation o.B.
Abdomen
Bauch weich, kein Druckschmerz
Darmgeräusche in allen 4 Quadranten hörbar
Keine Vergrößerung von Leber und Milz feststellbra
Kopf und Hals
Pupillen gleich, rund mit prompter Lichtreaktion
Schwellung im hinteren Pharynx
Schmerzhafte zervikale Lymphadenopathie
Bewegungsapparat
Bis auf Einschränkung in HWS unauffällig
Haut
Kein Ausschlag, keine Einblutungen
Neurologisch
Zeitlich, räumlich und zur Person orientiert
Keine motorischen Einschränkungen feststellbar
Labor
Das Labor zeigte eine Leukozytose, eine Thrombopenie sowie erhöhte Entzündungswerte.
| Lab Test | Result | Normal Value |
|---|---|---|
| Thrombozyten (/mcl) | 27.000 | 150.000–450.000 |
| Leukozyten (/mcl) | 13.900 | 4.500–10.000 |
| Erythrozyten (Mio./mcl) | 3,2 | 3,5-5 |
| Hämatokrit (%) | 25 | 37-47 |
| Hämoglobin (g/dl) | 11,8 | 12,0–16,0 |
| Kreatinin (mg/dl) | 1,0 | 0,6-1,1 |
| Kalium (mmol/L) | 3,0 | 3,5–5,0 |
| Natrium (mmol/l) | 133,0 | 135-145 |
| Kalzium (mmol/l) | 2,2 | 2,1-2,6 |
| CRP (mg/l) | 49 | <5 |
| BSG 1 (mm/h) | 31 | <20 |
| BSG 2 (mm/h) | 72 | 25-40 |
Weiterer Verlauf
Trotz Paracetamol i.v. stieg die Temperatur in der Folge auf 41,1°
und der Blutdruck fiel auf 86/40mmHg.
Nach Abnahme der Blutkulturen erhielt die Patientin 2g Ceftriaxon
Was wäre Ihr nächster diagnostischer Schritt?
Diagnose
Die Diagnose Lemierre Syndrom wurde gestellt
Das Lemierre-Syndrom ist eine seltene, potenziell lebensbedrohliche septische Thrombophlebitis der Vena jugularis interna, meist verursacht durch Fusobacterium necrophorum nach einer oropharyngealen Infektion (z. B. Tonsillitis, Pharyngitis).
Klinik:
- Initiale Halsschmerzen, Fieber
- Schwellung und Druckschmerz entlang des M. sternocleidomastoideus
- Septische Embolien (v. a. Lunge → multifokale Abszesse)
Diagnostik:
- Blutkulturen (anaerobe Erreger!)
- Doppler-Sonografie/CT-Angiografie der V. jugularis interna
Therapie:
- Breitbandantibiotika (z. B. Piperacillin/Tazobactam oder Carbapeneme)
- Antikoagulation (kontrovers, fallabhängig)
- Chirurgische Intervention (selten, bei therapieresistenter Thrombose)
Prognose:
- Hohe Mortalität ohne Therapie, gute Prognose bei früher Diagnosestellung und Behandlung.
Videostatement Prim. Univ.-Prof. Dr. Peter Schenk
Lorem ipsum dolor sit amet, consetetur sadipscing elitr, sed diam nonumy eirmod tempor invidunt ut labore et dolore magna aliquyam erat, sed diam voluptua. At vero eos et accusam et justo duo dolores et ea rebum. Stet clita kasd gubergren, no sea takimata sanctus est Lorem ipsum dolor sit amet.
Sie sehen gerade einen Platzhalterinhalt von Vimeo. Um auf den eigentlichen Inhalt zuzugreifen, klicken Sie auf die Schaltfläche unten. Bitte beachten Sie, dass dabei Daten an Drittanbieter weitergegeben werden.
Mehr InformationenWas würden Sie als nächsten Schritt tun?
Vielen Dank, dass sie unseren interaktiven Patientenfall durchgearbeitet haben!
Bereitgestellt von:
Piv.-Doz. Dr. med. Maximilian Österreicher
Facharzt für Innere Medizin und Rheumatologie, Notarzt
Redaktion:
Quellen
- Biofilms in lab and nature: a molecular geneticist’s voyage to microbial ecology.
Kolter R. Int Microbiol. 2010. PMID: 20890834 Review. - Neuronal FAM171A2 mediates α-synuclein fibril uptake and drives Parkinson’s disease.
Wu KM, et al. Science. 2025. PMID: 39977508 - Changing life expectancy in European countries 1990-2021: a subanalysis of causes and risk factors from the Global Burden of Disease Study 2021.
GBD 2021 Europe Life Expectancy Collaborators. Lancet Public Health. 2025. PMID: 39983748 - Reduced-volume radiotherapy versus conventional-volume radiotherapy after induction chemotherapy in nasopharyngeal carcinoma: An open-label, noninferiority, multicenter, randomized phase 3 trial.
Tang LL, et al. CA Cancer J Clin. 2025. PMID: 39970442 - Rift Valley fever virus coordinates the assembly of a programmable E3 ligase to promote viral replication.
Li H, et al. Cell. 2025. PMID: 39987918 No abstract available.
Tech Demo I
Eins
Lorem ipsum dolor sit amet, consetetur sadipscing elitr, sed diam nonumy eirmod tempor invidunt ut labore et dolore magna aliquyam erat, sed diam voluptua.
Drei
Lorem ipsum dolor sit amet, consetetur sadipscing elitr, sed diam nonumy eirmod tempor invidunt ut labore et dolore magna aliquyam erat, sed diam voluptua. At vero eos et accusam et justo duo dolores et ea rebum. Stet clita kasd gubergren, no sea takimata sanctus est Lorem ipsum dolor sit amet.
Vier
At vero eos et accusam et justo duo dolores et ea rebum. Stet clita kasd gubergren, no sea takimata sanctus est Lorem ipsum dolor sit amet.
Fünf
Lorem ipsum dolor sit amet, consetetur sadipscing elitr, sed diam nonumy eirmod tempor invidunt ut labore et dolore magna aliquyam erat, sed diam voluptua.
Tech Demo II
Lorem ipsum dolor sit amet, consetetur sadipscing elitr, sed diam nonumy eirmod tempor invidunt ut labore et dolore magna aliquyam erat, sed diam voluptua. At vero eos et accusam et justo duo dolores et ea rebum. Stet clita kasd gubergren, no sea takimata sanctus est Lorem ipsum dolor sit amet. Lorem ipsum dolor sit amet, consetetur sadipscing elitr, sed diam nonumy eirmod tempor invidunt ut labore et dolore magna aliquyam erat, se
elitr, sed diam nonumy eirmod tempor invidunt ut labore et dolore magna aliquyam erat, sed diam voluptua. At vero eos et accusam et justo duo dolores et ea rebum. Stet clita kasd gubergren, no sea takimata sanctus est Lorem ipsum dolor sit amet. Lorem ipsum dolor sit amet, consetetur sadipscing elitr, sed diam nonumy eirmod tempor invidunt ut labore et dolore magna aliquyam erat, sed diam voluptua. At vero eos et accusam et justo duo dolores et ea rebum. Stet clita kasd gubergren, no sea takimata sanctus est Lorem ipsum dolor sit amet.
Lorem ipsum dolor sit amet, consetetur sadipscing elitr, sed diam nonumy eirmod tempor invidunt ut labore et dolore magna aliquyam erat, sed diam voluptua. At vero eos et accusam et justo duo dolores et ea rebum. Stet clita kasd gubergren, no sea takimata sanctus est Lorem ipsum dolor sit amet. Lorem ipsum dolor sit amet, consetetur sadipscing elitr, sed diam nonumy eirmod tempor invidunt ut labore et dolore magna aliquyam erat, sed diam voluptua. At vero eos et accusam et justo duo dolores et ea rebum. Stet clita kasd gubergren, no sea takimata sanctus est Lorem ipsum dolor sit amet.
Stet clita kasd gubergren, no sea takimata sanctus est Lorem ipsum dolor sit amet. Lorem ipsum dolor sit amet, consetetur sadipscing elitr, sed diam nonumy eirmod tempor invidunt ut
Lorem ipsum dolor sit amet, consetetur sadipscing elitr, sed diam nonumy eirmod tempor invidunt ut labore et dolore magna aliquyam erat, sed diam voluptua. At vero eos et accusam et justo duo dolores et ea rebum.
, no sea takimata sanctus est Lorem ipsum dolor sit amet. Lorem ipsum dolor sit amet, consetetur sadipscing elitr, sed diam nonumy eirmod tempor invidunt ut labore et dolore magna aliquyam erat, sed diam voluptua. At vero eos et accusam et justo duo dolores et ea rebum. Stet clita kasd gubergren, no sea takimata sanctus est Lorem ipsum dolor sit amet.
Lorem ipsum dolor sit amet, consetetur sadipscing elitr, sed diam nonumy eirmod tempor invidunt ut labore et dolore magna aliquyam erat, sed diam voluptua. At vero eos et accusam et justo duo dolores et ea rebum. Stet clita kasd gubergren, no sea takimata sanctus est Lorem ipsum dolor sit amet.


























































































